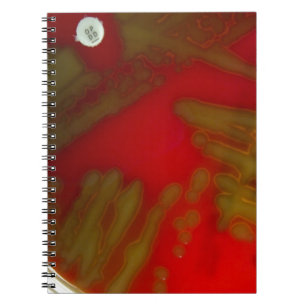
Penumonia Bacteria Notebook

Popular Science Gifts Notebooks
1,734 results
Another meeting notebook
Price$20.30
Planets, Stars and Rocket Ships Notebook
Price$46.25
Mini Bugs and Mini Beasts Notebook
Price$23.95
Space Ship Bueprint Notebook
Price$48.80
El Al Maslool Space Shuttle Notebook
Price$33.15
Biology typography and diagrams notebook
Price$21.40
Undocking Notebook
Price$33.15
Bound for Antares Notebook
Price$21.40
Craig and Ellie Notebook
Price$31.40
Flat Earth Notebook
Price$21.40
PHYSICS. IT'S THE LAW NOTEBOOK
Price$23.95
Sci-Fi Cyber Droid Fighter Pilot Notebook
Price$51.10
Penumonia Bacteria Notebook
Price$21.65
Blue Alien Harbour City Spiral Notebook
Price$21.20
Nerdy Atomic Notebook, Grey Notebook
Price$21.40
Neucragula Notebook
Price$48.80
Physics Notebook
Price$48.80
funny physicist definition notebook
Price$21.40
Green Spiral Graph Paper Composition Notebook
Price$33.15
Colourful Chemistry Flasks Pattern Notebook
Price$33.15
Truth Monster Notebook
Price$21.40
WEST INDIAN MANATEE NOTEBOOK
Price$20.30
Robot Ants Notebook
Price$33.90
ZOMBIE Face Notebook
Price$20.30
Hitchhiker's notebook
Price$21.40
nerd forever notebook
Price$21.40
i2 Keepin' It Real Notebook
Price$22.65
BIOLOGY HUMAN BODY & CELLS NOTEBOOK
Price$34.10
Abstract Subduction Zone Geology Notebook
Price$48.30
Be Happy! Serotonin Notebook
Price$21.40
Let's Go Darwin Notebook
Price$21.40
Zodiac Constellation Sagittarius Notebook
Price$33.15
Black Spiral Graph Paper Composition Notebook
Price$33.15
The Zazzle Promise
Love It Guarantee
Don't love it? We'll take it back! 30-day returns “100% Love It Guarantee.”
Easy International Delivery
No-hassle-free shipping with no surprise fees. We cover any customs & duties.
Secure Shopping Guaranteed
100% Secure payment with SSL Encryption.
Search Feedback
If you need help or have a question for Customer Service, please visit our Help Centre
Recently Viewed Items